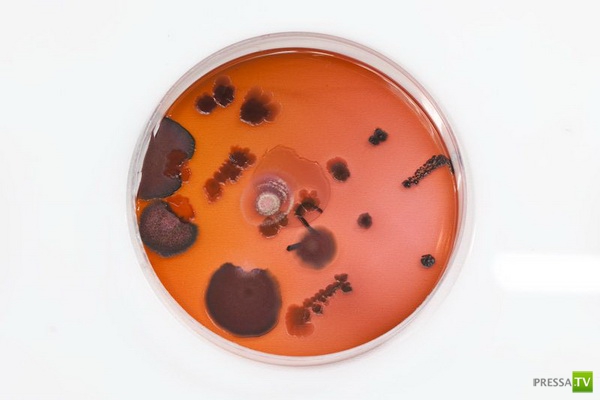
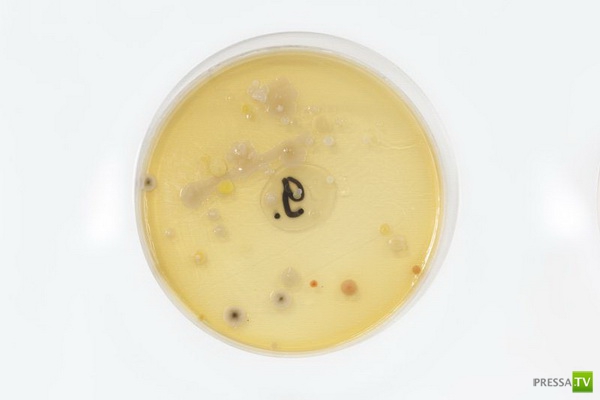

Осторожно!!! На деньгах живут бактерии (4 фото)
Вам, разумеется, не следует класть деньги себе в рот, потому что на них обитает великое множество самых разных бактерий. Мы просто не можем их видеть. По крайней мере, так было до тех пор, пока Сорин Попеску, 23-летний студент-фармацевт из Румынии, не собрал некоторое количество этих бактерий и не создал арт-проект, призванный «продемонстрировать всё то зло, которое несут в себе деньги». Он называется «Жизнь на деньгах», примерно как «Жизнь на Марсе».

В чём заключался процесс твоего проекта?
Я собрал бактерии с денег, а затем вырастил их с помощью специальной жидкости в чашках Петри. Обычно им дают 24 часа на размножение для большинства научных целей, но я позволил им развиваться гораздо дольше. Они росли до тех пор, пока не съели всё внутри чашек, высохли и умерли.

Как долго живут бактерии на деньгах?
Бактерии обычно переносятся двумя или тремя людьми, которые касались денег. Без питания они погибают. Стафилококк может прожить без питания намного дольше, и поэтому он может быть более опасным, чем другие.

Если кто-нибудь прикоснётся к деньгам, которые ты использовал в своём эксперименте – он заразится?
Да, все эти деньги были заражены. Я обнаружил множество разных бактерий, вроде кишечной палочки, Staphylococcus Aureus, Staphylococcus Albus, Neisseria, а также энтерококков. Все они вызывают различные заболевания и инфекции кровотока, мочеиспускательного тракта, лёгких, и даже могут вызывать сепсис или менингит. Так что все они не очень приятны.


В чём заключался процесс твоего проекта?
Я собрал бактерии с денег, а затем вырастил их с помощью специальной жидкости в чашках Петри. Обычно им дают 24 часа на размножение для большинства научных целей, но я позволил им развиваться гораздо дольше. Они росли до тех пор, пока не съели всё внутри чашек, высохли и умерли.
Как долго живут бактерии на деньгах?
Бактерии обычно переносятся двумя или тремя людьми, которые касались денег. Без питания они погибают. Стафилококк может прожить без питания намного дольше, и поэтому он может быть более опасным, чем другие.
Если кто-нибудь прикоснётся к деньгам, которые ты использовал в своём эксперименте – он заразится?
Да, все эти деньги были заражены. Я обнаружил множество разных бактерий, вроде кишечной палочки, Staphylococcus Aureus, Staphylococcus Albus, Neisseria, а также энтерококков. Все они вызывают различные заболевания и инфекции кровотока, мочеиспускательного тракта, лёгких, и даже могут вызывать сепсис или менингит. Так что все они не очень приятны.



